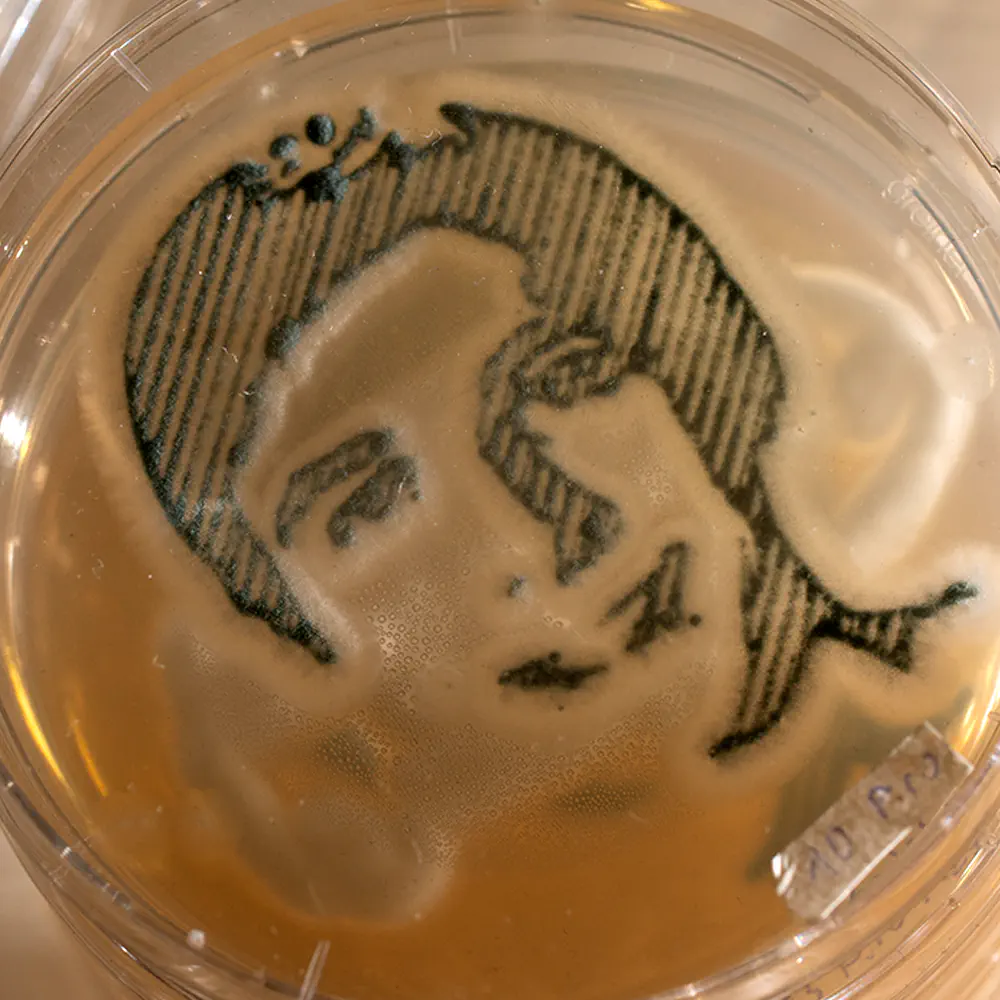

Mold Printer
Wolfgang Schwendtbauer & Valentin Postl

An exploration into bio-art that interfaces between digital and analog. The Mold Printer creates living images that emerge from invisibly small fungal spores.
These images are created not from printer ink but developed from living matter. A digital design is transformed into an image that is entirely unique and will only reveal itself through time. Mold images develop from invisibly small spores on a transparent growth medium. They happily grow at room temperature - no incubator required. Just hang them onto the wall end enjoy. Typically, the first dots will appear after only a day.
The Mold Printer was created as a master’s thesis project at the University of Applied Sciences Upper Austria with help from mycologists at the University Research Center Tulln.
Funggo Episode 1: Schimmelbilder Zuhause machen
Watch on YouTube

A Kids-TV inspired explainer video on how mold images are created (German)


The framework for the mold printer is a modified 3D printer that has been fitted with a motorized syringe holder. The printer firmware is unmodified and executes the same G-code instructions as a standard 3D printer. We have used both custom software and conventional 3D printing software to create the G-code for our images. A tiny amount of mold spores suspended in soapy water is injected underneath the surface of the growth medium. Images can either be created by poking individual dots or dragging continuous lines. Multicolor designs can be created by using different strains of mold and printing in multiple passes.